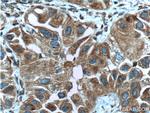
ASNA1 Antibody in Immunohistochemistry (Paraffin) (IHC (P))

Search
Proteintech
ASNA1 Monoclonal Antibody (1B7C11)
{{$productOrderCtrl.translations['antibody.pdp.commerceCard.promotion.promotions']}}
{{$productOrderCtrl.translations['antibody.pdp.commerceCard.promotion.viewpromo']}}
{{$productOrderCtrl.translations['antibody.pdp.commerceCard.promotion.promocode']}}: {{promo.promoCode}} {{promo.promoTitle}} {{promo.promoDescription}}. {{$productOrderCtrl.translations['antibody.pdp.commerceCard.promotion.learnmore']}}
产品信息
66346-1-IG
种属反应
宿主/亚型
分类
类型
克隆号
抗原
偶联物
形式
浓度
规格
纯化类型
保存液
内含物
保存条件
运输条件
产品详细信息
Immunogen sequence: MAAGVAGWG VEAEEFEDAP DVEPLEPTLS NIIEQRSLKW IFVGGKGGVG KTTCSCSLAV QLSKGRESVL IISTDPAHNI SDAFDQKFSK VPTKVKGYDN LFAMEIDPSL GVAELPDEFF EEDNMLSMGK KMMQEAMSAF PGIDEAMSYA EVMRLVKGMN FSVVVFDTAP TGHTLRLLNF PTIVERGLGR LMQIKNQISP FISQMCNMLG LGDMNADQLA SKLEETLPVI RSVSEQFKDP EQTTFICVCI AEFLSLYETE RLIQELAKCK IDTHNIIVNQ LVFPDPEKPC KMCEARHKIQ AKYLDQMEDL YEDFHIVKLP LLPHEVRGAD KVNTFSALLL EPYKPPSAQ (1-348 aa encoded by BC002651 )
靶标信息
ASNA1 is the human homolog of the bacterial arsA gene. In E. coli, ArsA ATPase is the catalytic component of a multisubunit oxyanion pump that is responsible for resistance to arsenicals and antimonials.
仅用于科研。不用于诊断过程。未经明确授权不得转售。
篇参考文献 (0)
生物信息学
蛋白别名: arsA arsenite transporter, ATP-binding, homolog 1; Arsenical pump-driving ATPase; Arsenite-stimulated ATPase; arsenite-translocating ATPase; ATPase ASNA1; ATPase GET3; golgi to ER traffic 3 homolog; Guided entry of tail-anchored proteins factor 3, ATPase; hARSA-I; hASNA-I; MGC3821; similar to bacterial and mouse ArsA; Transmembrane domain recognition complex 40 kDa ATPase subunit; unnamed protein product
基因别名: 1810048H22Rik; ARSA; ARSA-I; ARSA1; ASNA-I; ASNA1; CMD2H; GET3; TRC40
UniProt ID: (Mouse) O54984, (Rat) G3V9T7, (Human) O43681
Entrez Gene ID: (Mouse) 56495, (Rat) 288919, (Pig) 100520362, (Human) 439